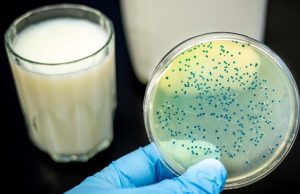

Cuma, Haziran 12, 2026
Türk Tıp, Eczacılık, Özel Sağlık, Hastane ve İlaç Sektöründe Gündemi Yakalayan Paylaşım Sitesi.
İletişim: [email protected]
© WinAlly'dan izinsiz özgün içeriklerinden kopyalama-içerik alımı yapılamaz yasal hakları saklıdır.
Bu site Tıp, Sağlık, Eczacılık ve İlaç Sektörü profesyonellerine yöneliktir, olası doğabilecek problemlerden WinAlly sorumlu değildir.Copyright © 2017